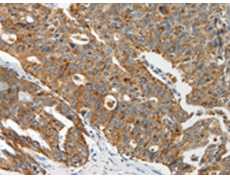
一抗

中文名稱: 兔抗ABCD2多克隆抗體
英文名稱: Anti-ABCD2 rabbit polyclonal antibody
別 名: ALDR; ABC39; ALDL1; ALDRP; hALDR
相關(guān)類別: 一抗
儲 存: 冷凍(-20℃)
宿 主: Rabbit
抗 原: ABCD2
反應(yīng)種屬: Human, Mouse, Rat
標 記 物: Unconjugate
克隆類型: rabbit polyclonal
技術(shù)規(guī)格
|
Background: |
The protein encoded by this gene is a member of the superfamily of ATP-binding cassette (ABC) transporters. ABC proteins transport various molecules across extra- and intra-cellular membranes. ABC genes are divided into seven distinct subfamilies (ABC1, MDR/TAP, MRP, ALD, OABP, GCN20, White). This protein is a member of the ALD subfamily, which is involved in peroxisomal import of fatty acids and/or fatty acyl-CoAs in the organelle. All known peroxisomal ABC transporters are half transporters which require a partner half transporter molecule to form a functional homodimeric or heterodimeric transporter. The function of this peroxisomal membrane protein is unknown; however this protein is speculated to function as a dimerization partner of ABCD1 and/or other peroxisomal ABC transporters. Mutations in this gene have been observed in patients with adrenoleukodystrophy, a severe demyelinating disease. This gene has been identified as a candidate for a modifier gene, accounting for the extreme variation among adrenoleukodystrophy phenotypes. This gene is also a candidate for a complement group of Zellweger syndrome, a genetically heterogeneous disorder of peroxisomal biogenesis. |
|
Applications: |
ELISA, IHC |
|
Name of antibody: |
ABCD2 |
|
Immunogen: |
Synthetic peptide of human ABCD2 |
|
Full name: |
ATP-binding cassette, sub-family D (ALD), member 2 |
|
Synonyms: |
ALDR; ABC39; ALDL1; ALDRP; hALDR |
|
SwissProt: |
Q9UBJ2 |
|
ELISA Recommended dilution: |
2000-5000 |
|
IHC positive control: |
Human ovarian cancer and Human thyroid cancer |
|
IHC Recommend dilution: |
25-100 |

 購物車
購物車 幫助
幫助
 021-54845833/15800441009
021-54845833/15800441009